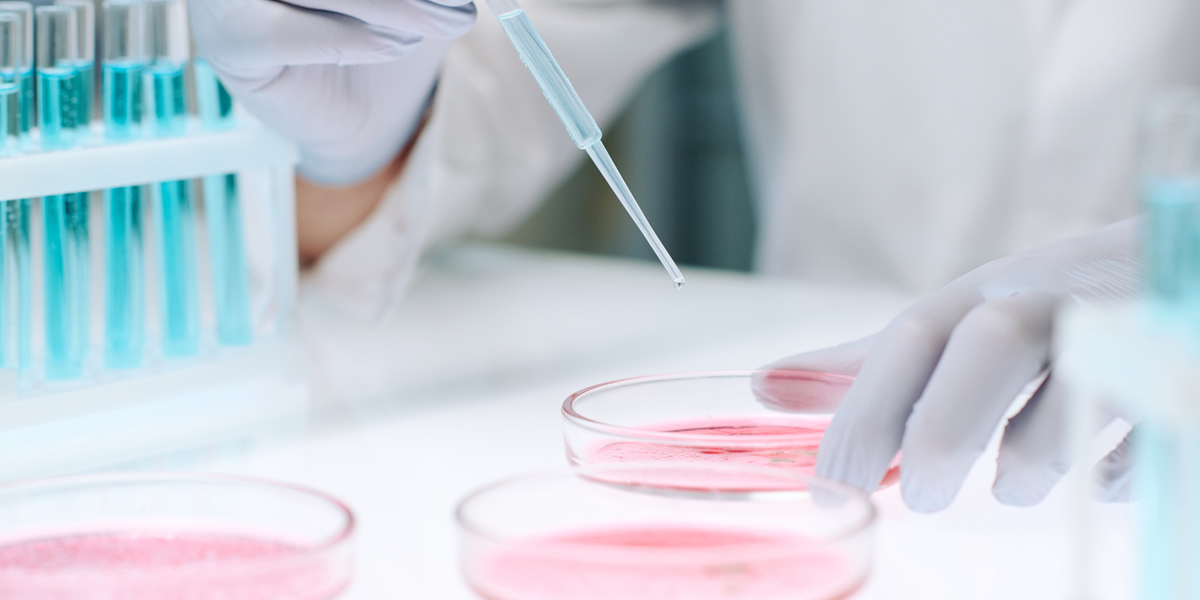

メニュー
Menu
ヴィーナス京都の提供メニューをご紹介します

ヴィーナス京都が提供する各メニューをご紹介します。
健康寿命を延ばし、人生そのものをより豊かにするための医療。これこそが、ヴィーナス京都の使命です。
訪問美容医療メニュー
気軽に始められる訪問型アンチエイジング医療。
まずはご自宅で安心して体験できる人気の美容医療メニューをご用意しました。専門のパーソナルナースがご自宅や職場に訪問し、肌や体にやさしく働きかけるケアやヘルス検査を実施いたします。
お問い合わせ・ご予約はこちらから
お気軽にご連絡ください